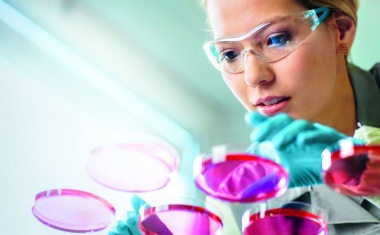
Photo

07.04.2020 • News
Four Parx: Ökologisch, moderner Gewerbepark bei München geplant
Four Parx plant einen Gewerbepark bei München.

Four Parx plant einen Gewerbepark bei München.
Österreichische Forscher des Austrian Centre of Industrial Biotechnology (acib), der Universität Innsbruck und der BOKU Wien entwickeln eine Plattformtechnologie, mit der die Pharmaindustrie sowohl die Suche und mögliche Produktion potenzieller SARS-CoV-2-Wirkstoffe beschleunigen und sicherstellen kann.






Die Biopharmazie ist Jobmotor in Deutschland.

































